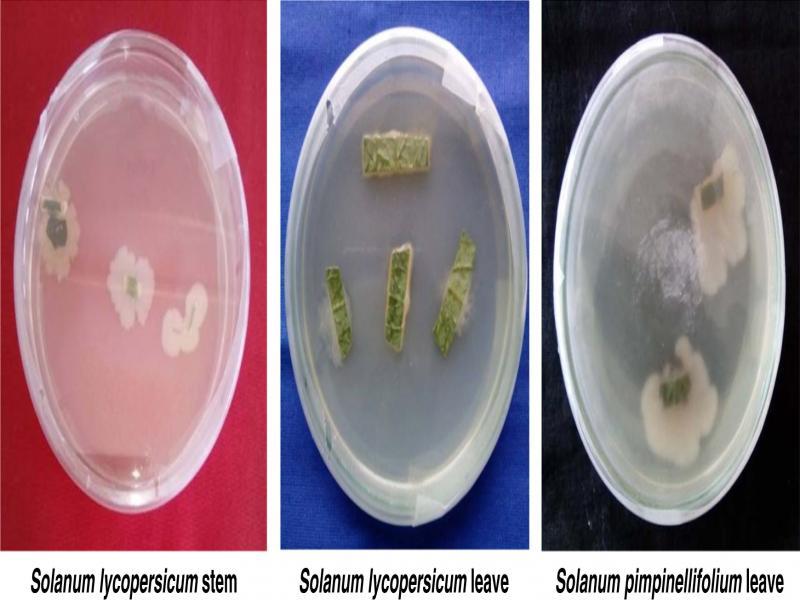
Growth of endophytic bacteria from cut pieces of stem and leaf on NA media. Solanum lycopersicum stem Solanum lycopersicum leave Solanum pimpinellifolium leave.

Figure 1:
Figure S1:

Figure S2:

Figure S3:

Figure S4:

Figure 2:

Figure 3:

Figure 4:

Figure 5:

Figure 6:

Figure 7:

Endophytic bacterial isolates from Solanum lycopersicum and Solanum pimpinellifolium_
| Source | Tissue | No. of isolates | Name of isolates |
|---|---|---|---|
| Solanum lycopersicum | leaf | 8 | BETL1, BETL2, BETL3, BETL4, BETL5, BETL6, BETL7 and BETL8 |
| S. lycopersicum | stem | 2 | BETS1 and BETS2 |
| Solanum pimpinellifolium (konbilahi) | leaf | 5 | BEKL1, BEKL2, BEKL3, BEKL4 and BEKL5 |
Effect of culture filtrate of isolated bacterial endophytes on juvenile mortality of Meloidogyne incognita_
| Period of exposure (hrs) | |||||||
|---|---|---|---|---|---|---|---|
| Treatment | Culture filtrate concentration | 6 | 12 | 24 | 48 | Treatment (T) Mean | Culture filtrate concentration (C) Mean |
| BETL1 | S/10 | 58.00 (49.61) | 64.00 (53.18) | 75.33 (60.23) | 80.67 (63.96) | 79.07 (63.64)c | 47.24 (42.36) |
| S/6 | 66.67 (54.86) | 71.33 (57.67) | 78.00 (62.04) | 84.00 (66.48) | 55.78 (47.70) | ||
| S/4 | 72.00 (58.09) | 78.67 (62.51) | 80.00 (63.49) | 88.67 (70.53) | 63.09 (52.62) | ||
| S/2 | 73.33 (61.60) | 82.00 (64.96) | 84.67 (66.97) | 92.00 (73.94) | 69.79 (57.62) | ||
| S | 81.33 (64.49) | 86.67 (68.70) | 88.67 (70.53) | 95.33 (78.90) | 76.51 (63.12) | ||
| BETL2 | S/10 | 54.67 (47.68) | 66.00 (54.34) | 76.67 (61.16) | 84.67 (67.08) | 81.47 (66.74)a | |
| S/6 | 60.00 (50.79) | 72.00 (58.09) | 80.67 (64.05) | 90.00 (71.76) | |||
| S/4 | 64.00 (53.14) | 78.00 (62.04) | 85.33 (67.61) | 94.00 (76.11) | |||
| S/2 | 78.00 (62.23) | 85.33 (67.61) | 91.33 (72.95) | 100.00 (89.93) | |||
| S | 83.33 (65.99) | 89.33 (71.06) | 95.33 (78.90) | 100.00 (89.93) | |||
| BETL3 | S/10 | 8.00 (16.35) | 22.00 (27.90) | 44.00 (41.52) | 60.67 (51.19) | 49.07 (44.17)m | |
| S/6 | 10.67 (18.93) | 28.00 (31.78) | 47.33 (43.47) | 64.00 (53.14) | |||
| S/4 | 19.33 (26.04) | 38.00 (37.99) | 60.67 (51.18) | 70.67 (57.25) | |||
| S/2 | 26.00 (30.63) | 52.67 (46.53) | 67.33 (55.15) | 78.00 (62.09) | |||
| S | 50.00 (45.00) | 67.33 (55.28) | 80.67 (63.93) | 86.00 (68.11) | |||
| BETS1 | S/10 | 26.67 (31.04) | 48.67 (44.23) | 63.33 (52.75) | 76.67 (61.23) | 65.90 (55.13)jk | |
| S/6 | 31.33 (33.98) | 52.00 (46.15) | 72.00 (58.13) | 80.00 (63.49) | |||
| S/4 | 35.33 (36.45) | 62.67 (52.36) | 78.00 (62.09) | 82.67 (65.45) | |||
| S/2 | 40.00 (39.22) | 69.33 (56.41) | 80.00 (63.49) | 88.67 (70.63) | |||
| S | 67.33 (55.15) | 80.67 (63.96) | 89.33 (71.06) | 93.33 (75.23) | |||
| BETL4 | S/10 | 52.00 (46.15) | 64.00 (53.14) | 72.67 (58.50) | 82.00 (64.96) | 81.43 (66.62)ab | |
| S/6 | 61.33 (51.59) | 72.67 (58.50) | 80.00 (63.46) | 86.00 (68.11) | |||
| S/4 | 70.00 (56.85) | 79.33 (63.00) | 87.33 (69.24) | 91.33 (72.95) | |||
| S/2 | 76.67 (61.27) | 85.33 (67.51) | 93.33 (75.23) | 97.33 (82.77) | |||
| S | 86.67 (68.70) | 91.33 (72.95) | 100.00 (89.93) | 100.00 (89.93) | |||
| BETL5 | S/10 | 31.33 (34.01) | 46.00 (42.69) | 50.67 (45.38) | 67.33 (55.21) | 64.20 (53.72)l | |
| S/6 | 40.00 (39.20) | 57.33 (49.22) | 66.00 (54.42) | 70.67 (57.39) | |||
| S/4 | 46.67 (43.06) | 66.00 (54.34) | 72.67 (58.50) | 77.33 (61.60) | |||
| S/2 | 48.67 (44.23) | 72.67 (58.50) | 78.00 (62.09) | 82.00 (64.99) | |||
| S | 62.00 (51.96) | 78.00 (62.14) | 82.67 (65.45) | 88.00 (69.93) | |||
| BETL6 | S/10 | 52.00 (46.15) | 60.67.00 (51.21) | 72.67 (58.55) | 80.67 (63.96) | 78.17 (63.56)de | |
| S/6 | 60.67 (51.17) | 70.00 (56.80) | 78.00 (62.09) | 84.00 (66.48) | |||
| S/4 | 66 (54.39) | 76.67 (61.16) | 82.67 (65.45) | 89.33 (71.06) | |||
| S/2 | 72.00 (58.14) | 80.00 (63.46) | 88.00 (69.93) | 94.67 (78.21) | |||
| S | 78.67 (62.56) | 86.00 (68.11) | 90.67 (72.36) | 100.00 (89.93) | |||
| BEKL1 | S/10 | 19.33 (25.92) | 26.00 (30.54) | 65.33 (53.97) | 76.67 (61.18) | 67.20 (56.23)h | |
| S/6 | 36.00 (36.84) | 42.67 (40.78) | 74.67 (59.83) | 80.67 (63.99) | |||
| S/4 | 44.00 (41.52) | 48.67 (44.23) | 80.00 (63.53) | 84.67 (67.08) | |||
| S/2 | 65.33 (53.97) | 76.00 (60.69) | 82.67 (65.58) | 89.33 (71.06) | |||
| S | 81.33 (64.45) | 87.33 (69.24) | 88.67 (70.53) | 94.67 (79.60) | |||
| BETS2 | S/10 | 42.00 (40.39) | 66.00 (54.36) | 70.67 (57.27) | 83.33 (65.94) | 78.87 (65.15)cd | |
| S/6 | 51.33 (45.76) | 71.33 (57.68) | 80.67 (64.05) | 87.33 (69.50) | |||
| S/4 | 60.00 (50.78) | 80.67 (63.96) | 86.00 (68.11) | 90.00 (71.76) | |||
| S/2 | 70.67 (57.27) | 84.00 (66.48) | 90.67 (72.36) | 96.67 (81.88) | |||
| S | 82.67 (65.45) | 88.67 (70.53) | 94.67 (78.21) | 100.00 (89.93) | |||
| BEKL2 | S/10 | 22.67 (28.30) | 29.33 (32.77) | 44.00 (41.55) | 68.67 (55.99) | 73.33 (60.72)f | |
| S/6 | 60.00 (50.80) | 69.33 (56.45) | 79.33 (62.99) | 85.33 (67.57) | |||
| S/4 | 68.67 (55.99) | 76.00 (60.74) | 84.00 (66.48) | 89.33 (71.42) | |||
| S/2 | 72.00 (58.09) | 80.67 (63.96) | 88.67 (70.47) | 94.67 (78.21) | |||
| S | 77.33 (61.65) | 84.00 (66.48) | 92.67 (74.53) | 100.00 (89.93) | |||
| BETL7 | S/10 | 18.00 (25.01) | 30.67 (33.61) | 51.33 (45.77) | 70.67 (57.28) | 66.23 (55.37)j | |
| S/6 | 27.33 (31.47) | 41.33 (39.99) | 61.33 (51.57) | 80.67 (64.05) | |||
| S/4 | 54.00 (47.31) | 70.00 (56.85) | 76.67 (61.14) | 85.33 (67.51) | |||
| S/2 | 68.00 (55.56) | 75.33 (60.25) | 83.33 (65.94) | 91.33 (72.95) | |||
| S | 76.00 (60.69) | 81.33 (64.49) | 87.33 (69.24) | 94.66 (76.81) | |||
| BEKL3 | S/10 | 14.00 (21.89) | 33.33 (35.24) | 57.33 (49.23) | 73.33 (58.99) | 67.19 (56.08)hi | |
| S/6 | 36.00 (36.86) | 46.67 (43.08) | 71.33 (57.67) | 79.33 (63.15) | |||
| S/4 | 52.00 (46.15) | 61.33 (51.61) | 82.00 (64.99) | 86.67 (68.70) | |||
| S/2 | 66.00 (54.34) | 73.33 (58.94) | 86.00 (68.37) | 90.67 (72.36) | |||
| S | 70.67 (57.23) | 80.00 (63.46) | 89.33 (71.06) | 94.67 (78.21) | |||
| BEKL4 | S/10 | 15.33 (22.92) | 42.67 (40.78) | 64.67 (53.55) | 82.00 (64.99) | 71.33 (59.95)g | |
| S/6 | 20.67 (26.94) | 54.67 (47.68) | 78.00 (62.09) | 87.33 (69.24) | |||
| S/4 | 34.00 (35.61) | 66.67 (54.79) | 88.00 (69.93) | 92.67 (74.53) | |||
| S/2 | 66.00 (54.36) | 80.00 (63.46) | 91.33 (73.24) | 96.67 (80.67) | |||
| S | 82.67 (65.49) | 88.67 (70.53) | 94.67 (78.21) | 100.00 (89.93) | |||
| BETL8 | S/10 | 16.00 (23.51) | 22.00 (27.90) | 28.00 (31.91) | 36.00 (36.86) | 37.07 (37.25)o | |
| S/6 | 21.33 (27.46) | 26.00 (30.63) | 32.67 (34.84) | 42.67 (40.78) | |||
| S/4 | 27.33 (31.49) | 31.33 (34.03) | 38.00 (38.04) | 49.33 (44.62) | |||
| S/2 | 32.67 (34.84) | 36.67 (37.26) | 46.67 (43.08) | 54.00 (47.31) | |||
| S | 40.00 (39.22) | 46.00 (42.70) | 52.67 (46.53) | 62.00 (52.01) | |||
| BEKL5 | S/10 | 20.67 (27.03) | 25.33 (30.19) | 30.67 (33.61) | 35.33 (36.46) | 39.20 (38.61)n | |
| S/6 | 26.67 (31.07) | 30.67 (33.61) | 36.00 (36.84) | 40.00 (39.22) | |||
| S/4 | 30.00 (33.19) | 35.33 (36.46) | 42.67 (40.77) | 46.67 (43.08) | |||
| S/2 | 35.33 (36.46) | 42.00 (40.39) | 48.67 (44.23) | 52.67 (46.53) | |||
| S | 41.33 (40.01) | 49.33 (44.62) | 55.33 (48.07) | 59.33 (50.39) | |||
| Distilled Water (SDW) | S | 0 | 0 | 0 | 0 | (0.00) | |
| S | 0 | 0 | 0 | 0 | |||
| S | 0 | 0 | 0 | 0 | |||
| S | 0 | 0 | 0 | 0 | |||
| S | 0 | 0 | 0 | 0 | |||
| Period of Exposure(t) Mean | 46.93 (42.16) | 58.28 (49.34) | 68.51 (56.29) | 76.23 (62.95) | |||
Morphological and biochemical characteristics of the isolated strains of endophytic bacteria_
| Isolated strains | Colour | Grams’ staining | Shape | Motility | KOH | Citrate utilization | Gelatin hydrolysis | Catalase test | Starch hydrolysis |
|---|---|---|---|---|---|---|---|---|---|
| BETL1 | Orange | +ve | Rod | + | -ve | +ve | +ve | +ve | -ve |
| BETL2 | Shiny yellow | +ve | Rod | + | -ve | -ve | +ve | +ve | -ve |
| BETL3 | Dark yellow | -ve | Rod | + | +ve | +ve | +ve | +ve | +ve |
| BETS1 | Yellow | -ve | Rod | + | +ve | -ve | +ve | +ve | -ve |
| BETL4 | White | +ve | Rod | + | -ve | +ve | +ve | +ve | +ve |
| BETL5 | Yellow | -ve | Diplococcus | + | +ve | -ve | +ve | +ve | -ve |
| BETL6 | Shiny yellow | +ve | Rod | + | -ve | +ve | +ve | +ve | -ve |
| BEKL1 | White | -ve | Coccus | + | +ve | +ve | +ve | +ve | -ve |
| BETS2 | Yellowish orange | +ve | Rod | + | -ve | -ve | +ve | +ve | +ve |
| BEKL2 | Cream | -ve | Rod | + | +ve | +ve | +ve | +ve | +ve |
| BETL7 | White | -ve | Coccus | + | +ve | +ve | +ve | +ve | +ve |
| BEKL3 | Yellow | -ve | Diplococcus | + | +ve | +ve | +ve | +ve | -ve |
| BEKL4 | Cream | -ve | Coccus | + | +ve | +ve | +ve | +ve | -ve |
| BETL8 | Cream | +ve | Rod | + | -ve | +ve | +ve | +ve | +ve |
| BEKL5 | Yellow | -ve | Rod | + | +ve | +ve | +ve | +ve | -ve |